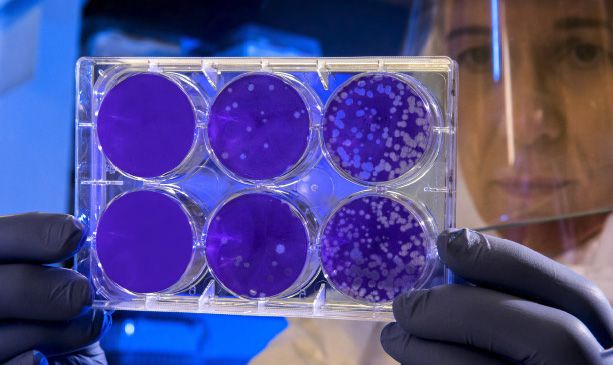

Channels
Special Offers & Promotions
Metrohm AG
Products
Contact Metrohm AG
All articles from Metrohm AG
New whitepaper: How online chemical analysis can help maximize efficiency of chlor-alkali production
Oct 9, 2019
Metrohm Autolab Partners with Arbin Instruments to Create an Integrated Solution for Battery Research
Jun 20, 2019
Metrohm Releases the Mira DS - a New Handheld Material Identification System for First Responders
Mar 22, 2018
Metrohm USA Collaborates with ASTM to Release New Test Method Measuring Harmful Organic Chlorides in Crude Oil
Feb 26, 2018
Metrohm Releases New Autosampler and Significant Upgrade to its 915, 916 and 917 Ti-Touch Titrators
Oct 25, 2017
Metrohm Collaborates with the ASTM to Release New Method for Analyzing Liquid Petroleum Gas
Jun 8, 2017
New, modular system enables multi-method analysis of chemical parameters on a single platform
Jun 27, 2016
What's suppression in ion chromatography all about? Theoretical aspects and practical benefits explained.
Jun 30, 2014
VoltIC pro combines ion chromatography and voltammetry in a single, powerful system for trace ion analysis
Sep 20, 2012
Permanganate index: fully automatic determination according to DIN EN ISO 8467 (DIN 38409-5)
Apr 13, 2012
ALS laboratory in Hong Kong automates titrimetric analysis with Metrohm 855 Robotic Titrosampler
Apr 11, 2012
WesTrac Group uses Metrohm analyzers to check oils and lubricants in Caterpillar machinery
Feb 22, 2012
Big contract lab in Germany uses automated thermometric titration to determine TAN and TBN in oils and lubricants
Feb 13, 2012
PILS-IC-VA: semi-continuous determination of anions, cations & heavy metals in aerosols
Oct 26, 2011
Comparative evaluation confirms superior performance of Metrohm electrode for pH measurement in fuel ethanol
Aug 31, 2011
Metrohm combines conductivity and pH measurement with Inline Dilution and subsequent ion chromatography (IC)
Aug 17, 2011
Intelligence meets precision: automated ion chromatography over six orders of magnitude
Mar 21, 2011
Simultaneous determination of fluoride species plus acid anions in etching baths by ion chromatography
Nov 25, 2010
Automatic determination of the hydroxyl number (HN) according to ASTM E 1899-08 and DIN 53240-2
Dec 11, 2009
Media Partners


 Metrohm is proud to announce the launch of the i-Raman NxG, a next-generation laboratory Raman spectrometer designed to enhance precision and performance in routine quality control measurements. The i-Raman NxG continues Metrohm's tradition of quality, offering advanced features that enable faster measurements, improved sensitivity, and greater sampling flexibility...
Metrohm is proud to announce the launch of the i-Raman NxG, a next-generation laboratory Raman spectrometer designed to enhance precision and performance in routine quality control measurements. The i-Raman NxG continues Metrohm's tradition of quality, offering advanced features that enable faster measurements, improved sensitivity, and greater sampling flexibility... Metrohm Spectro is pleased to announce the latest update to the Metrohm Comprehensive Raman Library (MCRL). This release represents a significant upgrade for TacticID, MIRA XTR and i-Raman systems, with over 27,749 entries. This release of the MCRL includes additional sub-libraries to support dedicated material identification analyzers for organic chemicals, narcotics and polymers...
Metrohm Spectro is pleased to announce the latest update to the Metrohm Comprehensive Raman Library (MCRL). This release represents a significant upgrade for TacticID, MIRA XTR and i-Raman systems, with over 27,749 entries. This release of the MCRL includes additional sub-libraries to support dedicated material identification analyzers for organic chemicals, narcotics and polymers... Metrohm USA is proud to announce the winner of the 2025 Young Chemist Award, Ms. Elham Akbari, a graduate student from Temple University. This year’s award, increased to $15,000 to reflect Metrohm’s growing commitment to fostering scientific innovation, honors Ms. Akbari’s outstanding research on thermal treatment methods for the destruction of per- and polyfluoroalkyl substances (PFAS), often referred to as "forever chemicals...
Metrohm USA is proud to announce the winner of the 2025 Young Chemist Award, Ms. Elham Akbari, a graduate student from Temple University. This year’s award, increased to $15,000 to reflect Metrohm’s growing commitment to fostering scientific innovation, honors Ms. Akbari’s outstanding research on thermal treatment methods for the destruction of per- and polyfluoroalkyl substances (PFAS), often referred to as "forever chemicals... The new OMNIS NIRS enhances the platform's versatility, enabling comprehensive chemical analysis through a single system. The introduction of OMNIS NIRS brings three specialized configurations to cater to different sample types: OMNIS NIRS Liquid for liquid samples, OMNIS NIRS Solid for solid and viscous materials, and OMNIS NIRS Liquid/Solid for dual sample analysis...
The new OMNIS NIRS enhances the platform's versatility, enabling comprehensive chemical analysis through a single system. The introduction of OMNIS NIRS brings three specialized configurations to cater to different sample types: OMNIS NIRS Liquid for liquid samples, OMNIS NIRS Solid for solid and viscous materials, and OMNIS NIRS Liquid/Solid for dual sample analysis... Metrohm is pleased to announce the release of their new website dedicated to the identification of fentanyl. idfentanyl.com is an overview of Metrohm’s capability to detect and identify fentanyl using Raman spectroscopy. This site demonstrates the power of Raman products from Metrohm in various real-world situations – where clear, accurate answers are essential. Fentanyl is often mixed with safe everyday items for distribution...
Metrohm is pleased to announce the release of their new website dedicated to the identification of fentanyl. idfentanyl.com is an overview of Metrohm’s capability to detect and identify fentanyl using Raman spectroscopy. This site demonstrates the power of Raman products from Metrohm in various real-world situations – where clear, accurate answers are essential. Fentanyl is often mixed with safe everyday items for distribution... Metrohm is pleased to introduce the new Metrohm Comprehensive Raman Library. This collection of over 16,200 substances simplifies material identification for customers in diverse industries and broadens applications for handheld and laboratory Raman. Built upon the foundations of the Illicit and Common Materials Library and the USP Certified Compounds Library, this library is one of the largest collections of Raman spectra available...
Metrohm is pleased to introduce the new Metrohm Comprehensive Raman Library. This collection of over 16,200 substances simplifies material identification for customers in diverse industries and broadens applications for handheld and laboratory Raman. Built upon the foundations of the Illicit and Common Materials Library and the USP Certified Compounds Library, this library is one of the largest collections of Raman spectra available... Metrohm USA is pleased to announce the winner of its 2023 Young Chemist Award, Manish Samson. Manish is an undergraduate student at The University of Texas at Dallas, Department of Bioengineering in the Biomedical Microdevices and Nanotechnology Laboratory under Dr. Shalini Prasad. His research focuses on developing portable, point-of-care electrochemical biosensors for the detection of pesticides and other environmental contaminants in field-deployed conditions...
Metrohm USA is pleased to announce the winner of its 2023 Young Chemist Award, Manish Samson. Manish is an undergraduate student at The University of Texas at Dallas, Department of Bioengineering in the Biomedical Microdevices and Nanotechnology Laboratory under Dr. Shalini Prasad. His research focuses on developing portable, point-of-care electrochemical biosensors for the detection of pesticides and other environmental contaminants in field-deployed conditions... Metrohm DropSens is pleased to announce the launch of the new µStat-i MultiX for flexible electrochemical analysis. This instrument is designed for multi-user and multi-disciplinary laboratory research teams. The MultiX combines a multichannel bipotentiostat, galvanostat and impedance analyzer (MultiplEIS® technology) into one convenient platform. The instrument boasts an improved user experience for multi-user and multi-disciplinary electrochemical research...
Metrohm DropSens is pleased to announce the launch of the new µStat-i MultiX for flexible electrochemical analysis. This instrument is designed for multi-user and multi-disciplinary laboratory research teams. The MultiX combines a multichannel bipotentiostat, galvanostat and impedance analyzer (MultiplEIS® technology) into one convenient platform. The instrument boasts an improved user experience for multi-user and multi-disciplinary electrochemical research... Metrohm USA is pleased to announce the winner of its 2022 Young Chemist Award, Colby Ott. Colby is a Ph.D. candidate at West Virginia University's Forensic and Investigative Science Department in Morgantown, West Virginia, where his research centers around developing novel methods for screening seized drugs. His work aims to provide reliable and rapid detection in the laboratory and the field, with future applications in forensics, clinical healthcare, and toxicology...
Metrohm USA is pleased to announce the winner of its 2022 Young Chemist Award, Colby Ott. Colby is a Ph.D. candidate at West Virginia University's Forensic and Investigative Science Department in Morgantown, West Virginia, where his research centers around developing novel methods for screening seized drugs. His work aims to provide reliable and rapid detection in the laboratory and the field, with future applications in forensics, clinical healthcare, and toxicology... Metrohm is excited to announce the opening of a new office in New Jersey. The new facility will house development, production and manufacturing space for Metrohm Group companies Innovative Photonic Solutions and B&W Tek. It is located in the heart of the U.S. pharmaceutical market and will also serve as a field office for Metrohm USA. Metrohm has been growing its footprint in the spectroscopy market in recent years and is proud to announce its latest investment...
Metrohm is excited to announce the opening of a new office in New Jersey. The new facility will house development, production and manufacturing space for Metrohm Group companies Innovative Photonic Solutions and B&W Tek. It is located in the heart of the U.S. pharmaceutical market and will also serve as a field office for Metrohm USA. Metrohm has been growing its footprint in the spectroscopy market in recent years and is proud to announce its latest investment... Metrohm USA and Metrohm Canada are pleased to announce that they have entered into a non-exclusive agreement with Agilent Technologies to become a value-added reseller for their single- and triple-quadrupole mass spectrometers as well as ICP-MS and ICP-OES products, software and services. This new partnership significantly expands the ion chromatography (IC) capabilities of Metrohm USA and Metrohm Canada and opens numerous additional applications...
Metrohm USA and Metrohm Canada are pleased to announce that they have entered into a non-exclusive agreement with Agilent Technologies to become a value-added reseller for their single- and triple-quadrupole mass spectrometers as well as ICP-MS and ICP-OES products, software and services. This new partnership significantly expands the ion chromatography (IC) capabilities of Metrohm USA and Metrohm Canada and opens numerous additional applications... Metrohm DropSens has announced new capabilities that facilitate the high-volume production of customized electrochemical sensors. Custom sensors are manufactured through a highly scalable and cost-effective manufacturing process with virtually no quantity limits. Metrohm DropSens supports the entire development and production process, from initial conceptualization to in-depth prototype design....
Metrohm DropSens has announced new capabilities that facilitate the high-volume production of customized electrochemical sensors. Custom sensors are manufactured through a highly scalable and cost-effective manufacturing process with virtually no quantity limits. Metrohm DropSens supports the entire development and production process, from initial conceptualization to in-depth prototype design.... Point-of-care (POC) testing with screen-printed electrodes allows rapid testing of populations for viral outbreaks – at affordable costs, without the need for trained specialists and/or complicated equipment. A free white paper from Metrohm puts a focus on the viability of electrochemical testing citing a number of recent studies on the possibility of POC testing for viruses of various kinds....
Point-of-care (POC) testing with screen-printed electrodes allows rapid testing of populations for viral outbreaks – at affordable costs, without the need for trained specialists and/or complicated equipment. A free white paper from Metrohm puts a focus on the viability of electrochemical testing citing a number of recent studies on the possibility of POC testing for viruses of various kinds.... Metrohm is pleased to present the new handheld 913 pH/DO Meter and the 914 pH/DO/Conductometer. The new, combined meters feature the O2-Lumitrode. Due to its very short response time, this optical sensor for measuring the concentration of dissolved oxygen in water or any other liquid is the fastest of its kind on the market....
Metrohm is pleased to present the new handheld 913 pH/DO Meter and the 914 pH/DO/Conductometer. The new, combined meters feature the O2-Lumitrode. Due to its very short response time, this optical sensor for measuring the concentration of dissolved oxygen in water or any other liquid is the fastest of its kind on the market.... The universal digital platform from Metrohm integrates the latest laboratory balance from Sartorius.
The universal digital platform from Metrohm integrates the latest laboratory balance from Sartorius.  Metrohm USA is pleased to announce the winner of its 2020 Young Chemist Award, Dr. Pawan Jolly. Pawan is a Senior Research Scientist at Harvard’s Wyss Institute where he works under the supervision of Donald E. Ingber, MD, PhD, Director Wyss Institute for Biologically Inspired Engineering at Harvard University. Pawan’s research focuses on developing an anti-fouling sensor coating to be used in low cost diagnostic tools....
Metrohm USA is pleased to announce the winner of its 2020 Young Chemist Award, Dr. Pawan Jolly. Pawan is a Senior Research Scientist at Harvard’s Wyss Institute where he works under the supervision of Donald E. Ingber, MD, PhD, Director Wyss Institute for Biologically Inspired Engineering at Harvard University. Pawan’s research focuses on developing an anti-fouling sensor coating to be used in low cost diagnostic tools.... 'Metrohm' has always meant state-of-the-art technology for the chemical laboratory. For many scientists, we have also been a preferred partner to help find or develop solutions for specific application challenges. We would like to share the highlights of our application know-how with the world, and that is why, as of this year, we will start blogging about many interesting topics geared towards our scientific readership....
'Metrohm' has always meant state-of-the-art technology for the chemical laboratory. For many scientists, we have also been a preferred partner to help find or develop solutions for specific application challenges. We would like to share the highlights of our application know-how with the world, and that is why, as of this year, we will start blogging about many interesting topics geared towards our scientific readership.... Spectroelectrochemistry is the combination of electrochemistry and spectroscopy and studies spectral changes as a function of applied potential or current. When combining both techniques, the limited structural information available from the electrochemical response is complemented by optical monitoring. Launching SPELEC, Metrohm DropSens is proud to present the first fully integrated range of instruments for spectroelectrochemical research...
Spectroelectrochemistry is the combination of electrochemistry and spectroscopy and studies spectral changes as a function of applied potential or current. When combining both techniques, the limited structural information available from the electrochemical response is complemented by optical monitoring. Launching SPELEC, Metrohm DropSens is proud to present the first fully integrated range of instruments for spectroelectrochemical research... Chlorine and caustic soda are produced together in large quantities primarily through the chlor-alkali process, mainly via the membrane cell electrolysis method. This white paper describes the key focal points of membrane electrolysis and shows how real-time monitoring of critical chemical parameters can help improve robustness and increase efficiency of the chlor-alkali production process....
Chlorine and caustic soda are produced together in large quantities primarily through the chlor-alkali process, mainly via the membrane cell electrolysis method. This white paper describes the key focal points of membrane electrolysis and shows how real-time monitoring of critical chemical parameters can help improve robustness and increase efficiency of the chlor-alkali production process.... What’s the difference between High Performance Liquid Chromatography (HPLC) and Ion Chromatography (IC)? What are the capabilities and limitations of each technique? Knowing these differences can actually make a huge difference. As a proven, robust and highly versatile technique, IC can help HPLC users extend their analytical capabilities tremendously. Our free white paper compares the two methods systematically focusing on the strengths of ion chromatography....
What’s the difference between High Performance Liquid Chromatography (HPLC) and Ion Chromatography (IC)? What are the capabilities and limitations of each technique? Knowing these differences can actually make a huge difference. As a proven, robust and highly versatile technique, IC can help HPLC users extend their analytical capabilities tremendously. Our free white paper compares the two methods systematically focusing on the strengths of ion chromatography.... One of the biggest players from the aerospace industry has replaced chromium in their anodizing process of aircraft parts by a mix of sulfuric and tartaric acid (TSA, Tartaric Sulfuric Anodizing). Metrohm developed a new method allowing this customer to determine both acids quickly and reliably using the same sensor, a highly sensitive, fast responding thermometer. An Application Note is available free of charge....
One of the biggest players from the aerospace industry has replaced chromium in their anodizing process of aircraft parts by a mix of sulfuric and tartaric acid (TSA, Tartaric Sulfuric Anodizing). Metrohm developed a new method allowing this customer to determine both acids quickly and reliably using the same sensor, a highly sensitive, fast responding thermometer. An Application Note is available free of charge.... Metrohm Autolab and Arbin Instruments have combined their decades of experience to launch a new Electrochemical Impedance Spectroscopy (EIS) solution that can easily be integrated into any battery testing program. Incorporating EIS into battery research and cell testing provides better insight into battery performance and degradation mechanisms, which improves the accuracy and reliability of the analysis....
Metrohm Autolab and Arbin Instruments have combined their decades of experience to launch a new Electrochemical Impedance Spectroscopy (EIS) solution that can easily be integrated into any battery testing program. Incorporating EIS into battery research and cell testing provides better insight into battery performance and degradation mechanisms, which improves the accuracy and reliability of the analysis.... 'Pushing the limits together' – that’s the claim of Metrohm Process Analytics, the brand of the global Metrohm Group’s subsidiary catering specifically to the process industry. Customized online analyzers from Metrohm Process Analytics allow customers to monitor key quality parameters in multiple process streams in order to increase product yield, reduce costs, and comply with safety and environmental regulations.
'Pushing the limits together' – that’s the claim of Metrohm Process Analytics, the brand of the global Metrohm Group’s subsidiary catering specifically to the process industry. Customized online analyzers from Metrohm Process Analytics allow customers to monitor key quality parameters in multiple process streams in order to increase product yield, reduce costs, and comply with safety and environmental regulations. The acquisition of B&W Tek LLC by Metrohm AG in July 2018 has created one of the largest solution providers for applied Raman spectroscopy. Beginning May 1, 2019, Metrohm USA and Metrohm Canada will begin selling B&W Tek mobile spectroscopy solutions. The addition of the B&W Tek products complements Metrohm’s existing Raman and near-IR solutions for lab and....
The acquisition of B&W Tek LLC by Metrohm AG in July 2018 has created one of the largest solution providers for applied Raman spectroscopy. Beginning May 1, 2019, Metrohm USA and Metrohm Canada will begin selling B&W Tek mobile spectroscopy solutions. The addition of the B&W Tek products complements Metrohm’s existing Raman and near-IR solutions for lab and.... Ambient air quality is critical for our health and the environment. According to the World Health Organization 91% of the world population lives in places where the WHO air quality guideline levels are not met. To monitor the air quality, Metrohm Process Analytics has re-invented the well-known Monitor for AeRosols and Gases in ambient Air (MARGA) as the 2060 MARGA.
Ambient air quality is critical for our health and the environment. According to the World Health Organization 91% of the world population lives in places where the WHO air quality guideline levels are not met. To monitor the air quality, Metrohm Process Analytics has re-invented the well-known Monitor for AeRosols and Gases in ambient Air (MARGA) as the 2060 MARGA. USP<645> describes conductivity as key parameter for measuring the purity of ultrapure water and water for injection. Compliance with USP<645> is key for manufacturers from the pharmaceutical industry. However, following the three stage test procedure defined by the standard can be a challenge, particularly if the testing is performed manually. A dedicated Metrohm system provides a fully automated solution to this challenge reducing the risk of error while increasing productivity....
USP<645> describes conductivity as key parameter for measuring the purity of ultrapure water and water for injection. Compliance with USP<645> is key for manufacturers from the pharmaceutical industry. However, following the three stage test procedure defined by the standard can be a challenge, particularly if the testing is performed manually. A dedicated Metrohm system provides a fully automated solution to this challenge reducing the risk of error while increasing productivity.... Metrohm USA is pleased to announce the winner of its 2019 Young Chemist Award, Jeffrey Lopez. Jeffrey is a postdoctoral fellow at Massachusetts Institute of Technology (MIT) where he works under the supervision of Prof. Zhenan Bao, the K.K. Lee Professor of Chemical Engineering, and by courtesy Professor of Chemistry, Materials Science and Engineering. Jeffrey’s research focuses on stabilizing lithium...
Metrohm USA is pleased to announce the winner of its 2019 Young Chemist Award, Jeffrey Lopez. Jeffrey is a postdoctoral fellow at Massachusetts Institute of Technology (MIT) where he works under the supervision of Prof. Zhenan Bao, the K.K. Lee Professor of Chemical Engineering, and by courtesy Professor of Chemistry, Materials Science and Engineering. Jeffrey’s research focuses on stabilizing lithium... The acquisition of B&W Tek LLC by Swiss Metrohm AG in July 2018 creates one of the largest solution providers for applied Raman spectroscopy. Two technology leaders in the field of Raman spectroscopy join forces, and customers all over the world will benefit: That is the key message that Metrohm and B&W Tek are addressing to the market. In addition to the well-established distribution network of B&W Tek, selected Metrohm subsidiaries have started supplying the full range of the B&W Tek product line.
The acquisition of B&W Tek LLC by Swiss Metrohm AG in July 2018 creates one of the largest solution providers for applied Raman spectroscopy. Two technology leaders in the field of Raman spectroscopy join forces, and customers all over the world will benefit: That is the key message that Metrohm and B&W Tek are addressing to the market. In addition to the well-established distribution network of B&W Tek, selected Metrohm subsidiaries have started supplying the full range of the B&W Tek product line. The competition for the Metrohm Young Chemist Award came to a close lately with the three winners visiting Metrohm International Headquarters in Switzerland. From there, Sophia Oukala (France), Antonella Giarra (Italy), and Bibekananda De (India) went on a guided tour all over Switzerland. On the program were destinations such as the European Organization for Nuclear Research (CERN), the Gotthard Base Tunnel, Mt. Saentis – and lots of Swiss cheese....
The competition for the Metrohm Young Chemist Award came to a close lately with the three winners visiting Metrohm International Headquarters in Switzerland. From there, Sophia Oukala (France), Antonella Giarra (Italy), and Bibekananda De (India) went on a guided tour all over Switzerland. On the program were destinations such as the European Organization for Nuclear Research (CERN), the Gotthard Base Tunnel, Mt. Saentis – and lots of Swiss cheese.... Operators of wastewater treatment plants depend on reliable methods to monitor plant performance. Metrohm is pleased to present a collection of standardized methods (ISO, DIN, EPA) for critical parameters ranging from chemical oxygen demand (COD), to alkalinity, oxyhalides, and heavy metals. The mentioned brochure is free of charge and describes methods such as DIN 38409-44 (Chemical oxygen demand), DIN 38406-3 (Total hardness, Ca2+, Mg2+), EPA 300.1, Part B (Oxyhalides)....
Operators of wastewater treatment plants depend on reliable methods to monitor plant performance. Metrohm is pleased to present a collection of standardized methods (ISO, DIN, EPA) for critical parameters ranging from chemical oxygen demand (COD), to alkalinity, oxyhalides, and heavy metals. The mentioned brochure is free of charge and describes methods such as DIN 38409-44 (Chemical oxygen demand), DIN 38406-3 (Total hardness, Ca2+, Mg2+), EPA 300.1, Part B (Oxyhalides).... Heroin and other opioids pose a threat to communities all over the world. Drug enforcement and forensic laboratories need fast, efficient methods that can be used to identify these substances
Heroin and other opioids pose a threat to communities all over the world. Drug enforcement and forensic laboratories need fast, efficient methods that can be used to identify these substances  One of the main goals of the USP monograph modernization initiative is to replace non-specific methods with highly selective and sensitive instrumental analysis methods. Based on a joint project with Metrohm, the USP proposes a new ion chromatography method for chloride and sulfate detection in drug substances, potassium carbonate, and potassium bicarbonate. The method is described in a free technical poster....
One of the main goals of the USP monograph modernization initiative is to replace non-specific methods with highly selective and sensitive instrumental analysis methods. Based on a joint project with Metrohm, the USP proposes a new ion chromatography method for chloride and sulfate detection in drug substances, potassium carbonate, and potassium bicarbonate. The method is described in a free technical poster.... USP and Metrohm jointly developed a potentiometric titration method for potassium bicarbonate and potassium carbonate assay. The new method uses autotitration combined with suitable equivalence point detection fulfilling all USP method validation requirements as per USP General Chapter <1225>. Many of the chemical medicine assay procedures are done by manual titration as per USP monographs. The manual titration procedure lacks data integrity and is prone to human error...
USP and Metrohm jointly developed a potentiometric titration method for potassium bicarbonate and potassium carbonate assay. The new method uses autotitration combined with suitable equivalence point detection fulfilling all USP method validation requirements as per USP General Chapter <1225>. Many of the chemical medicine assay procedures are done by manual titration as per USP monographs. The manual titration procedure lacks data integrity and is prone to human error... IC-MS is a proven method for the highly sensitive and selective analysis of anions, oxoanions, herbicides, and pesticides. Metrohm enhances the benefits of this method by integrating inline sample preparation for more convenience, higher throughput, and better reproducibility of results. A technical poster gives an overview of the many possible applications. The Metrohm IC-MS method is dedicated to develop selective, sensitive, robust and accelerated applications for the detection of ions in matrix-loaded samples....
IC-MS is a proven method for the highly sensitive and selective analysis of anions, oxoanions, herbicides, and pesticides. Metrohm enhances the benefits of this method by integrating inline sample preparation for more convenience, higher throughput, and better reproducibility of results. A technical poster gives an overview of the many possible applications. The Metrohm IC-MS method is dedicated to develop selective, sensitive, robust and accelerated applications for the detection of ions in matrix-loaded samples.... The Metrohm jubilee year 2018 culminates with a highlight: The three winners of the global competition for the Metrohm Young Chemist Award have been nominated and invited to visit Metrohm International Headquarters in Switzerland. Metrohm has always valued the spirit of innovation and believes in the value of novel research performed by young scientists. Throughout this year, young chemist all over the world had the chance to apply with their research and compete for the Metrohm Young Chemist Award in their home countries...
The Metrohm jubilee year 2018 culminates with a highlight: The three winners of the global competition for the Metrohm Young Chemist Award have been nominated and invited to visit Metrohm International Headquarters in Switzerland. Metrohm has always valued the spirit of innovation and believes in the value of novel research performed by young scientists. Throughout this year, young chemist all over the world had the chance to apply with their research and compete for the Metrohm Young Chemist Award in their home countries... Data integrity requires data to be complete, consistent, and accurate throughout their complete lifecycle, providing full transparency and traceability. Industry guidelines such as ALCOA and ALCOA+ describe these requirements, which are used by the FDA, WHO, PIC/S and GAMP. All major Metrohm software products make compliance with the ALCOA and ALCOA+ guidelines easy, for anyone. As regulation becomes stricter, safeguarding the quality of data produced along the manufacturing process and the protection of such data against loss...
Data integrity requires data to be complete, consistent, and accurate throughout their complete lifecycle, providing full transparency and traceability. Industry guidelines such as ALCOA and ALCOA+ describe these requirements, which are used by the FDA, WHO, PIC/S and GAMP. All major Metrohm software products make compliance with the ALCOA and ALCOA+ guidelines easy, for anyone. As regulation becomes stricter, safeguarding the quality of data produced along the manufacturing process and the protection of such data against loss... Metrohm is pleased to present the latest compliant handheld Raman solution for the pharmaceutical industry. Mira P offers enhanced resolution, new immersion sampling and validation accessories, and ergonomic features that improve user experience. Mira P is fast, easy, and accurate helping users optimize the inspection of incoming goods, formulation verification, and process monitoring. Mira P and its dedicated software, MiraCal P was developed in collaboration with some of the world’s leading pharmaceutical companies...
Metrohm is pleased to present the latest compliant handheld Raman solution for the pharmaceutical industry. Mira P offers enhanced resolution, new immersion sampling and validation accessories, and ergonomic features that improve user experience. Mira P is fast, easy, and accurate helping users optimize the inspection of incoming goods, formulation verification, and process monitoring. Mira P and its dedicated software, MiraCal P was developed in collaboration with some of the world’s leading pharmaceutical companies... Metrohm Process Analytics presents the new 2029 Process Photometer, an integrated solution for 24/7 online analysis of critical chemical parameters in industrial processes and wastewater streams. This single-method system performs photometric absorption measurements in the visible light range and is available in several application-specific configurations for monitoring up to 2 process streams.
Metrohm Process Analytics presents the new 2029 Process Photometer, an integrated solution for 24/7 online analysis of critical chemical parameters in industrial processes and wastewater streams. This single-method system performs photometric absorption measurements in the visible light range and is available in several application-specific configurations for monitoring up to 2 process streams. USP has updated the General Chapter <591> «Zinc Determination» monograph to include ion chromatography as the preferred method for measuring zinc oxide. USP 41–NF 36 was developed in partnership with Metrohm and replaces manual titration methods. The new method is approved by the FDA and benefits users with more ease of use and reliability. Zinc oxide is used in various skin care creams, drugs, and drug products....
USP has updated the General Chapter <591> «Zinc Determination» monograph to include ion chromatography as the preferred method for measuring zinc oxide. USP 41–NF 36 was developed in partnership with Metrohm and replaces manual titration methods. The new method is approved by the FDA and benefits users with more ease of use and reliability. Zinc oxide is used in various skin care creams, drugs, and drug products.... From August 28 through 30, 2019, Metrohm will be hosting the 3rd Global User Meeting IC in Herisau, Switzerland. The focus will be on latest developments in ion chromatography, which will be presented by our application specialists as well as guest speakers from various industries and academia....
From August 28 through 30, 2019, Metrohm will be hosting the 3rd Global User Meeting IC in Herisau, Switzerland. The focus will be on latest developments in ion chromatography, which will be presented by our application specialists as well as guest speakers from various industries and academia.... Waters™ leading chromatography data software (CDS), Empower™, increases versatility with the introduction of control for Metrohm ion chromatographs. Laboratories can now perform all their chromatographic applications (including ion chromatography) on one universal software platform. This provides the opportunity to increase efficiency, lower costs, and benefit from faster sample turnaround....
Waters™ leading chromatography data software (CDS), Empower™, increases versatility with the introduction of control for Metrohm ion chromatographs. Laboratories can now perform all their chromatographic applications (including ion chromatography) on one universal software platform. This provides the opportunity to increase efficiency, lower costs, and benefit from faster sample turnaround.... Metrohm is proud to announce the extension of its OMNIS titratorplatform to include a fully integrated solution for moisture analysis and water content determination with volumetric Karl Fischer titration. The OMNIS platform was first released in 2016, making it the only titration system on the market that increases efficiency by up to 60% through parallel titration...
Metrohm is proud to announce the extension of its OMNIS titratorplatform to include a fully integrated solution for moisture analysis and water content determination with volumetric Karl Fischer titration. The OMNIS platform was first released in 2016, making it the only titration system on the market that increases efficiency by up to 60% through parallel titration... Metrohm is pleased to present Mira DS, a new handheld material identification system for police, hazmat teams, bomb technicians, and military personnel. At the push of a button, Mira DS identifies illicit substances and explosives. Mira DS was developed in close cooperation with professional first responders. While providing ease of use and speed...
Metrohm is pleased to present Mira DS, a new handheld material identification system for police, hazmat teams, bomb technicians, and military personnel. At the push of a button, Mira DS identifies illicit substances and explosives. Mira DS was developed in close cooperation with professional first responders. While providing ease of use and speed... Metrohm is pleased to present a fully automated solution for the determination of Total Acid Number (TAN) and Total Base Number (TBN) in up to 112 samples. This solution is based on the OMNIS Sample Robot and addresses the needs of QC laboratories in the petrochemical industry as well as contract laboratories looking for an efficient solution to cope with high sample loads at the lowest possible cost per sample...
Metrohm is pleased to present a fully automated solution for the determination of Total Acid Number (TAN) and Total Base Number (TBN) in up to 112 samples. This solution is based on the OMNIS Sample Robot and addresses the needs of QC laboratories in the petrochemical industry as well as contract laboratories looking for an efficient solution to cope with high sample loads at the lowest possible cost per sample... Metrohm expands the OMNIS Titration Platform enabling users to perform volumetric Karl Fischer titrations. The OMNIS Karl Fischer Titrator addresses the needs of users for ease of use and protection from solvents and reagents with a whole range of innovative features. Safer – no risk of physical contact with solvents and reagents - with the OMNIS Karl Fischer Titrator, the complete analysis is performed in a closed system....
Metrohm expands the OMNIS Titration Platform enabling users to perform volumetric Karl Fischer titrations. The OMNIS Karl Fischer Titrator addresses the needs of users for ease of use and protection from solvents and reagents with a whole range of innovative features. Safer – no risk of physical contact with solvents and reagents - with the OMNIS Karl Fischer Titrator, the complete analysis is performed in a closed system.... Metrohm is proud to announce the release of its new handheld Raman material identification system Mira DS. Mira DS safely identifies illicit substances and explosives without the need for direct contact with the material in question, making it an ideal solution for police, hazmat teams, bomb technicians, and military personnel. The system was developed in close cooperation with professional first...
Metrohm is proud to announce the release of its new handheld Raman material identification system Mira DS. Mira DS safely identifies illicit substances and explosives without the need for direct contact with the material in question, making it an ideal solution for police, hazmat teams, bomb technicians, and military personnel. The system was developed in close cooperation with professional first... Metrohm USA is proud to announce
Metrohm USA is proud to announce  Metrohm USA welcomes its Tampa employees to their new North American headquarters in Riverview, Florida.
Metrohm USA welcomes its Tampa employees to their new North American headquarters in Riverview, Florida.  Metrohm USA is pleased to announce the winner of its 2018 Young Chemist Award, Chi-En Lin. Chi-En is a Ph.D. candidate at Arizona State University where he works under the mentorship of Dr. Jeffrey T. La Belle, Assistant Professor at the School of Biological and Health Systems Engineering.
Metrohm USA is pleased to announce the winner of its 2018 Young Chemist Award, Chi-En Lin. Chi-En is a Ph.D. candidate at Arizona State University where he works under the mentorship of Dr. Jeffrey T. La Belle, Assistant Professor at the School of Biological and Health Systems Engineering.  Metrohm is pleased to announce the acquisition of Innovative Photonic Solutions (IPS). With this important acquisition, Metrohm continues to invest in strategic growth and enhances the company’s capabilities to further develop a portfolio of industry-leading Raman solutions.IPS is the largest producer of Raman spectroscopy diode-based light components in the world. Founded in 2003, the company’s products range from simple components such as packaged diodes and OEM modules that include....
Metrohm is pleased to announce the acquisition of Innovative Photonic Solutions (IPS). With this important acquisition, Metrohm continues to invest in strategic growth and enhances the company’s capabilities to further develop a portfolio of industry-leading Raman solutions.IPS is the largest producer of Raman spectroscopy diode-based light components in the world. Founded in 2003, the company’s products range from simple components such as packaged diodes and OEM modules that include.... These releases will bring enhanced productivity to laboratories performing standard, routine titrations in support of product quality or manufacturing. The expanded capability of the Ti-Touch family and the 810 autosampler are particularly beneficial to users in regulated industries such as pharmaceutical and...
These releases will bring enhanced productivity to laboratories performing standard, routine titrations in support of product quality or manufacturing. The expanded capability of the Ti-Touch family and the 810 autosampler are particularly beneficial to users in regulated industries such as pharmaceutical and... Located just outside of Los Angeles, the new West Coast location supports the company’s mission to bring its market-leading technologies closer to customers. The 6,200 square foot office will feature a full laboratory for training and demonstrations and generous space for customer meetings....
Located just outside of Los Angeles, the new West Coast location supports the company’s mission to bring its market-leading technologies closer to customers. The 6,200 square foot office will feature a full laboratory for training and demonstrations and generous space for customer meetings.... A result of Metrohm’s long-term collaboration with industry leaders and the ASTM, this method helps customers in the energy and petrochemical markets to certify products for safe use. Further applications extend this method to help monitor industrial manufacturing equipment for evidence of corrosion....
A result of Metrohm’s long-term collaboration with industry leaders and the ASTM, this method helps customers in the energy and petrochemical markets to certify products for safe use. Further applications extend this method to help monitor industrial manufacturing equipment for evidence of corrosion.... Eco IC delivers performance and productivity for price sensitive markets such as environmental testing and higher education. Suitable for the routine analysis of anions, cations and polar substances, Eco IC uses Metrohm’s unique approach to ion chromatography to deliver faster separations, higher sensitivity and better method robustness, all while maintaining affordability....
Eco IC delivers performance and productivity for price sensitive markets such as environmental testing and higher education. Suitable for the routine analysis of anions, cations and polar substances, Eco IC uses Metrohm’s unique approach to ion chromatography to deliver faster separations, higher sensitivity and better method robustness, all while maintaining affordability.... Scheduled to be completed in early 2018, this nearly $20 million dollar facility will boast state-of-the-art laboratory and training facilities for Metrohm’s growing employee and customer-base. Metrohm is one of the world’s most trusted manufacturers of high-precision instruments for chemical analysis.....
Scheduled to be completed in early 2018, this nearly $20 million dollar facility will boast state-of-the-art laboratory and training facilities for Metrohm’s growing employee and customer-base. Metrohm is one of the world’s most trusted manufacturers of high-precision instruments for chemical analysis..... Based on method-driven software, the M-3 changes the landscape of handheld Raman, bringing the controls of a benchtop instrument to a handheld platform. The M-3 allows full adjustment of laser power, integration time, and data processing through customizable operating procedures. Unlike competitive handheld instruments that hide all control of data collection, the user is able to...
Based on method-driven software, the M-3 changes the landscape of handheld Raman, bringing the controls of a benchtop instrument to a handheld platform. The M-3 allows full adjustment of laser power, integration time, and data processing through customizable operating procedures. Unlike competitive handheld instruments that hide all control of data collection, the user is able to... Aldin is completing his graduate work at Arizona State University where he works under the supervision of Professor Michael Caplan, Chair of the Biomedical Engineering Department, and Assistant Professor Jeffrey LaBelle. Aldin’s research focuses on cooperative, DNA-based molecular elements for electrochemical biosensors.....
Aldin is completing his graduate work at Arizona State University where he works under the supervision of Professor Michael Caplan, Chair of the Biomedical Engineering Department, and Assistant Professor Jeffrey LaBelle. Aldin’s research focuses on cooperative, DNA-based molecular elements for electrochemical biosensors..... As a member of ASTM’s largest committee D02, the company helps develop test methods that ensure the safety of gasoline, diesel fuel, motor oil and liquid propane. Larry Tucker, Vice President of Business Development at Metrohm USA, leads the company’s efforts to work with the scientific community to solve common industry problems....
As a member of ASTM’s largest committee D02, the company helps develop test methods that ensure the safety of gasoline, diesel fuel, motor oil and liquid propane. Larry Tucker, Vice President of Business Development at Metrohm USA, leads the company’s efforts to work with the scientific community to solve common industry problems....
 With a detection limit of approximately 1 µg/L, the method is sensitive enough to comply with limit values in the US, Canada, Australia, and others. A free whitepaper provides more details on the method and its application. Glyphosate and its metabolite AMPA (aminomethylphosphonic acid) are usually determined by HPLC with post-column derivatization and subsequent fluorescence detection...
With a detection limit of approximately 1 µg/L, the method is sensitive enough to comply with limit values in the US, Canada, Australia, and others. A free whitepaper provides more details on the method and its application. Glyphosate and its metabolite AMPA (aminomethylphosphonic acid) are usually determined by HPLC with post-column derivatization and subsequent fluorescence detection...
 Performing 4 different titrations simultaneously on a single, fully automated system is the new state of the art in titration. The new OMNIS platform by Metrohm includes an x-y-z sample robot, taking the efficiency of wet chemical analysis to new levels....
Performing 4 different titrations simultaneously on a single, fully automated system is the new state of the art in titration. The new OMNIS platform by Metrohm includes an x-y-z sample robot, taking the efficiency of wet chemical analysis to new levels.... Part of Metrohm’s commitment to ongoing education and practical training, these half-day seminars are designed for anyone from a laboratory measuring moisture or water content or for those who are currently using other techniques for moisture analysis and would like to learn about KF techniques....
Part of Metrohm’s commitment to ongoing education and practical training, these half-day seminars are designed for anyone from a laboratory measuring moisture or water content or for those who are currently using other techniques for moisture analysis and would like to learn about KF techniques.... The mission of The Electrochemical Society is to advance theory and practice at the forefront of electrochemical and solid state science. Metrohm USA’s support helps ECS members make key discoveries that address challenges such as renewable energy, food safety, water sanitation, and medical diagnosis and care....
The mission of The Electrochemical Society is to advance theory and practice at the forefront of electrochemical and solid state science. Metrohm USA’s support helps ECS members make key discoveries that address challenges such as renewable energy, food safety, water sanitation, and medical diagnosis and care.... Quality control in many industries depends on the routine analysis of a handful of key parameters. Often, determination of these parameters is distributed across several technologies and methods. This goes along with cumbersome aggregation of results and management of data from different sources. With the launch of the new, modular OMNIS platform for comprehensive wet chemical analysis, this situation will change....
Quality control in many industries depends on the routine analysis of a handful of key parameters. Often, determination of these parameters is distributed across several technologies and methods. This goes along with cumbersome aggregation of results and management of data from different sources. With the launch of the new, modular OMNIS platform for comprehensive wet chemical analysis, this situation will change....
 Designed for routine analysis measurements, this new software includes an intuitive and self-explaining user interface for fast measurement and straightforward data interpretation. Operation focuses on sample analysis parameters and trends, not spectra, increasing the information density from NIR measurements. Using an integrated and powerful networking system, Vision Air provides maximum control over all connected...
Designed for routine analysis measurements, this new software includes an intuitive and self-explaining user interface for fast measurement and straightforward data interpretation. Operation focuses on sample analysis parameters and trends, not spectra, increasing the information density from NIR measurements. Using an integrated and powerful networking system, Vision Air provides maximum control over all connected... With the release of our new drivers Metrohm adds support for more sample handling accessories, IC systems with amperometric and conductivity detection and dual-channel systems for combined anion and cation analysis. Metrohm integrates with Empower to control all aspects of the system from a small volume autosampler to detection schemes. Users have the ability to determine anions, cations, and polar substances by ion...
With the release of our new drivers Metrohm adds support for more sample handling accessories, IC systems with amperometric and conductivity detection and dual-channel systems for combined anion and cation analysis. Metrohm integrates with Empower to control all aspects of the system from a small volume autosampler to detection schemes. Users have the ability to determine anions, cations, and polar substances by ion... Established in 1949 by the ASTM International Board of Directors, the Award of Merit is the highest society award granted to an individual member for distinguished service and outstanding participation in ASTM International committee activities. The Award of Merit was presented to Jay in recognition of his outstanding contributions to Committee D19 on Water through standardization of test methods and the management of inter-laboratory studies related to...
Established in 1949 by the ASTM International Board of Directors, the Award of Merit is the highest society award granted to an individual member for distinguished service and outstanding participation in ASTM International committee activities. The Award of Merit was presented to Jay in recognition of his outstanding contributions to Committee D19 on Water through standardization of test methods and the management of inter-laboratory studies related to... This compact, stand-alone coulometer offers several unique features that make it ideal for fast, precise determination of low-level water content. A vivid touchscreen display, simple method recall and an integrated pump combined with reagent and sample handling make the 917 compact coulometer the fastest and most convenient solution for routine moisture analysis. The new 917 Coulometer is intelligent - automatically recognizing...
This compact, stand-alone coulometer offers several unique features that make it ideal for fast, precise determination of low-level water content. A vivid touchscreen display, simple method recall and an integrated pump combined with reagent and sample handling make the 917 compact coulometer the fastest and most convenient solution for routine moisture analysis. The new 917 Coulometer is intelligent - automatically recognizing... Amay is completing his Ph.D. at the University of California San Diego where he works under the supervision of Professor Joseph Wang, SAIC Endowed Professor and Chair of the NanoEngineering Department. Amay’s research focuses on developing next generation of wearable sensors that, unlike today’s wearable devices, possess the power to continuously monitor physiologically relevant chemicals directly on the human body in a completely non-invasive fashion...
Amay is completing his Ph.D. at the University of California San Diego where he works under the supervision of Professor Joseph Wang, SAIC Endowed Professor and Chair of the NanoEngineering Department. Amay’s research focuses on developing next generation of wearable sensors that, unlike today’s wearable devices, possess the power to continuously monitor physiologically relevant chemicals directly on the human body in a completely non-invasive fashion...
 Suppression as a practical solution for ion chromatography
Suppression as a practical solution for ion chromatography The optrode features eight different wavelengths for a wide measuring range, it is 100% solvent resistant thanks to a glass shaft, and it is very easy to handle. The new photometric sensor can be used for many applications. Typical applications include....
The optrode features eight different wavelengths for a wide measuring range, it is 100% solvent resistant thanks to a glass shaft, and it is very easy to handle. The new photometric sensor can be used for many applications. Typical applications include.... Near-infrared spectroscopy (NIRS) offers numerous advantages over many wet-chemical analytical methods. A diverse range of parameters can be determined simultaneously with just one analysis. Metrohm NIRSystems are economical and fast, enabling qualitative and quantitative analyses that are noninvasive and nondestructive.NIRS is an indispensable analysis technique that can be used along the entire production chain – from incoming materials to processing to the quality control of finished products...
Near-infrared spectroscopy (NIRS) offers numerous advantages over many wet-chemical analytical methods. A diverse range of parameters can be determined simultaneously with just one analysis. Metrohm NIRSystems are economical and fast, enabling qualitative and quantitative analyses that are noninvasive and nondestructive.NIRS is an indispensable analysis technique that can be used along the entire production chain – from incoming materials to processing to the quality control of finished products... 'Electrodes in Voltammetry' comes on a single CD and answers all your questions concerning the installation and maintenance of the
'Electrodes in Voltammetry' comes on a single CD and answers all your questions concerning the installation and maintenance of the The analytical determination of chromium (VI) content in toys for compliance with limit values is described in the European standard DIN EN-71-3-2013 (Safety of toys Part 3 – Migration of certain elements). The standard differentiates between three categories, depending on the kind of toys...
The analytical determination of chromium (VI) content in toys for compliance with limit values is described in the European standard DIN EN-71-3-2013 (Safety of toys Part 3 – Migration of certain elements). The standard differentiates between three categories, depending on the kind of toys... The usual spectroscopic methods (ICP-MS, AAS) for the determination of toxic arsenic in drinking water are either very expensive or challenging to use. An alternative method that is much easier to use and much less expensive at the same time is voltammetric determination with the scTRACE Gold. This new, screenprinted sensor can be used without any preparation; measuring results are available after only 10 minutes on average, and the detection limit for arsenic is well below the 10 µg/L stipulated by the latest legislation in the US and the EU....
The usual spectroscopic methods (ICP-MS, AAS) for the determination of toxic arsenic in drinking water are either very expensive or challenging to use. An alternative method that is much easier to use and much less expensive at the same time is voltammetric determination with the scTRACE Gold. This new, screenprinted sensor can be used without any preparation; measuring results are available after only 10 minutes on average, and the detection limit for arsenic is well below the 10 µg/L stipulated by the latest legislation in the US and the EU....
 Superior flexibility, perfect ease of use, and outstanding reliability are key features of Metrohm’s new ion chromatograph for routine analysis. The 930 Compact IC Flex is entirely modular by design. Users can select from a comprehensive range of components to configure the custom solution they need to meet their particular analytical requirements. A new online configurator supports them in selecting from the numerous modules and component
Superior flexibility, perfect ease of use, and outstanding reliability are key features of Metrohm’s new ion chromatograph for routine analysis. The 930 Compact IC Flex is entirely modular by design. Users can select from a comprehensive range of components to configure the custom solution they need to meet their particular analytical requirements. A new online configurator supports them in selecting from the numerous modules and component

 The 940 Professional IC Vario is Metrohm’s most versatile IC system yet. Entirely modular by design, the 940 Professional IC Vario enables unlimited configuration possibilities and meets even the most challenging analytical requirements. The profile of Metrohm‘s new flagship in ion chromatography is completed by new features increasing usability and the legendary Metrohm product quality....
The 940 Professional IC Vario is Metrohm’s most versatile IC system yet. Entirely modular by design, the 940 Professional IC Vario enables unlimited configuration possibilities and meets even the most challenging analytical requirements. The profile of Metrohm‘s new flagship in ion chromatography is completed by new features increasing usability and the legendary Metrohm product quality.... Real-time measurements and simple operation make it the preferred solution for closed-loop automatic control enabling users to consistently run their production closer to target specifications. The NIRS Analyzer Pro analyzer is available with dedicated interfaces based on reflectance or transmittance technology whichever is best suited for each application area
Real-time measurements and simple operation make it the preferred solution for closed-loop automatic control enabling users to consistently run their production closer to target specifications. The NIRS Analyzer Pro analyzer is available with dedicated interfaces based on reflectance or transmittance technology whichever is best suited for each application area Less need for expensive consumables, outstanding warranties and integral, fully automated sample preparation will benefit users with lower running costs, more efficiency, and highly dependable Swiss technology - for routine analysis and research alike. Investing in Metrohm ion chromatography means routine analysis with fewer consumables such as syringe filters and filter caps required. Integral, fully automated sample preparation (inline dilution, inline calibration, inline dialysis) saves time and stress....
Less need for expensive consumables, outstanding warranties and integral, fully automated sample preparation will benefit users with lower running costs, more efficiency, and highly dependable Swiss technology - for routine analysis and research alike. Investing in Metrohm ion chromatography means routine analysis with fewer consumables such as syringe filters and filter caps required. Integral, fully automated sample preparation (inline dilution, inline calibration, inline dialysis) saves time and stress.... While the major focus is on water chemistry, the new brochure also presents methods for quality control of turbine oils, fuels, and operating materials. «Power plant analysis» spans the entire array of types of thermal power plants dealing with fossil-fueled plants and nuclear plants (BWR, PWR) alike...
While the major focus is on water chemistry, the new brochure also presents methods for quality control of turbine oils, fuels, and operating materials. «Power plant analysis» spans the entire array of types of thermal power plants dealing with fossil-fueled plants and nuclear plants (BWR, PWR) alike... In this alliance, we, Metrohm, will become the sole global distributor of FOSS NIR instruments for the chemical, petrochemical, pharmaceutical, and environmental sectors. In a nutshell, FOSS NIRSystems will become Metrohm NIRSystems. Metrohm has been known for top-quality solutions for wet chemical analysis for more than 60 years. Now, we are taking a step beyond, bringing to you the finest solutions for NIR Spectroscopy. Our enlarged portfolio gives you even more options to choose and find the perfect solution for your analytical requirements...
In this alliance, we, Metrohm, will become the sole global distributor of FOSS NIR instruments for the chemical, petrochemical, pharmaceutical, and environmental sectors. In a nutshell, FOSS NIRSystems will become Metrohm NIRSystems. Metrohm has been known for top-quality solutions for wet chemical analysis for more than 60 years. Now, we are taking a step beyond, bringing to you the finest solutions for NIR Spectroscopy. Our enlarged portfolio gives you even more options to choose and find the perfect solution for your analytical requirements... The new applications are freely available from the Metrohm website. The new ANs are...
The new applications are freely available from the Metrohm website. The new ANs are... Join us in this 3-day event and catch up with the latest analytical methods during presentations and practical demonstrations. Discuss challenges in environmental analysis with experts and colleagues from all over the world and enjoy three days of inspiring learning in the beautiful Appenzellerland. Participants will get to know the latest analytical solutions developed by Metrohm for environmental analysis and can test them in practice. There will be plenty of opportunities to exchange ideas and discuss questions with Metrohm’s application chemists as well as peers from research and various industries. Guest speakers include specialists from environmental laboratories, authorities, standards organizations, and academia...
Join us in this 3-day event and catch up with the latest analytical methods during presentations and practical demonstrations. Discuss challenges in environmental analysis with experts and colleagues from all over the world and enjoy three days of inspiring learning in the beautiful Appenzellerland. Participants will get to know the latest analytical solutions developed by Metrohm for environmental analysis and can test them in practice. There will be plenty of opportunities to exchange ideas and discuss questions with Metrohm’s application chemists as well as peers from research and various industries. Guest speakers include specialists from environmental laboratories, authorities, standards organizations, and academia...

 With CIC, unlike with alternative methods the concentrations of the different halogens can each be shown separately. Moreover, digestion by pyrolysis is superior to offline digestion methods with regard to sample throughput and precision and correctness of results...
With CIC, unlike with alternative methods the concentrations of the different halogens can each be shown separately. Moreover, digestion by pyrolysis is superior to offline digestion methods with regard to sample throughput and precision and correctness of results... Over the years, the Metrohm Rancimat has become the standard device for measuring the oxidation stability of natural oils and fats. In fact, the Rancimat is so popular that these days the corresponding test method goes by the name 'Rancimat method'. Metrohm is pleased to publish a range of new application notes on the fast and reliable determination of 12 natural oils and fats using the just released 892 Professional Rancimat...
Over the years, the Metrohm Rancimat has become the standard device for measuring the oxidation stability of natural oils and fats. In fact, the Rancimat is so popular that these days the corresponding test method goes by the name 'Rancimat method'. Metrohm is pleased to publish a range of new application notes on the fast and reliable determination of 12 natural oils and fats using the just released 892 Professional Rancimat... The user benefits of the fully automated VoltIC pro system are evident. Samples need to be prepared just once for comprehensive analysis by both techniques, i.e., ion chromatography and voltammetry. This saves considerable amounts of time. Moreover, Results for all parameters are presented in a single database for convenient handling and evaluation...
The user benefits of the fully automated VoltIC pro system are evident. Samples need to be prepared just once for comprehensive analysis by both techniques, i.e., ion chromatography and voltammetry. This saves considerable amounts of time. Moreover, Results for all parameters are presented in a single database for convenient handling and evaluation... The Metrohm Academy can boast the latest laboratory equipment, presentation and translation technologies, and is open to Metrohm distributors and customers alike. The Metrohm Academy's facilities comprise two training laboratories with a combined floor area of 200 m2, three seminar rooms with combined seating for almost 50 people, a special room for service training, and an auditorium with about 100 seats...
The Metrohm Academy can boast the latest laboratory equipment, presentation and translation technologies, and is open to Metrohm distributors and customers alike. The Metrohm Academy's facilities comprise two training laboratories with a combined floor area of 200 m2, three seminar rooms with combined seating for almost 50 people, a special room for service training, and an auditorium with about 100 seats... In the early 1980s ion chromatography was already around as an analytical technique. However, it was very expensive and also rather difficult to use. Metrohm set out to change this with an ion chromatograph engineered to be simple to use, robust, and above all, affordable. The result was the 690 ion chromatograph, which was launched in 1987. At the time it cost only half as much as the competition's instruments...
In the early 1980s ion chromatography was already around as an analytical technique. However, it was very expensive and also rather difficult to use. Metrohm set out to change this with an ion chromatograph engineered to be simple to use, robust, and above all, affordable. The result was the 690 ion chromatograph, which was launched in 1987. At the time it cost only half as much as the competition's instruments... Eight wavelengths for a wide measuring range (470, 502, 520, 574, 590, 610, 640 and 660 nm), 100% solvent resistance due to a glass shaft, and easy handling - these are the key-benefits of the Optrode, the new photometric sensor from Metrohm. Whenever a potentiometric determination of the equivalence point is impossible, but a simple and fast execution of the analyses with the price advantage of titration (compared to methods like AAS, ICP-AES) is wished for, the Optrode is the first choice...
Eight wavelengths for a wide measuring range (470, 502, 520, 574, 590, 610, 640 and 660 nm), 100% solvent resistance due to a glass shaft, and easy handling - these are the key-benefits of the Optrode, the new photometric sensor from Metrohm. Whenever a potentiometric determination of the equivalence point is impossible, but a simple and fast execution of the analyses with the price advantage of titration (compared to methods like AAS, ICP-AES) is wished for, the Optrode is the first choice... Metrohm presents the 899 Coulometer, the most compact and flexible Coulometer yet from Metrohm! Besides a footprint the size of just a DIN A4 sheet of paper, it comes with a Power Box for its own independent power supply! The 899 Coulometer does not need much space because it has its own magnetic stirrer built in. There is no need for a support rod either. An integrated holder keeps the titration cell safely standing on the upper side of the instrument...
Metrohm presents the 899 Coulometer, the most compact and flexible Coulometer yet from Metrohm! Besides a footprint the size of just a DIN A4 sheet of paper, it comes with a Power Box for its own independent power supply! The 899 Coulometer does not need much space because it has its own magnetic stirrer built in. There is no need for a support rod either. An integrated holder keeps the titration cell safely standing on the upper side of the instrument... Metrohm presents a method for completely automated determination of the permanganate index according to DIN EN ISO 8467 (DIN 38409-5). The new method not only saves time, but is robust and, because of the tiamoTM titration software, very easy to use. The permanganate index is used to evaluate the quality of different types of water, e.g. drinking water, mineral water, spring water, and table water. It is determined in accordance with DIN EN ISO 8467 (DIN 38409-5)...
Metrohm presents a method for completely automated determination of the permanganate index according to DIN EN ISO 8467 (DIN 38409-5). The new method not only saves time, but is robust and, because of the tiamoTM titration software, very easy to use. The permanganate index is used to evaluate the quality of different types of water, e.g. drinking water, mineral water, spring water, and table water. It is determined in accordance with DIN EN ISO 8467 (DIN 38409-5)... ALS is a global leader in the provision of analytical laboratory and technical services to international minerals, coal, environmental, tribology and industrial markets. At their large Hong Kong laboratory, ALS concentrates mainly on environmental analysis. In order to increase the lab's capacity ALS Hong Kong has automated acid-base titrations with an 855 Robotic Titrosampler from Metrohm...
ALS is a global leader in the provision of analytical laboratory and technical services to international minerals, coal, environmental, tribology and industrial markets. At their large Hong Kong laboratory, ALS concentrates mainly on environmental analysis. In order to increase the lab's capacity ALS Hong Kong has automated acid-base titrations with an 855 Robotic Titrosampler from Metrohm... Anyone who picks up a smartphone or tablet nowadays can almost take it for granted that it contains an HDI printed circuit board from AT&S, one of the world’s leading manufacturers of high-quality PCBs for the Mobile Devices sector. AT&S has concentrated the manufacture of these high-tech products at its plant in Shanghai. As far as the monitoring and optimization of the coating process in the acidic copper bath are concerned, wet chemical analytical techniques such as titration and cyclic voltammetric stripping (CVS) play an important role. In this area AT&S in Shanghai relies on systems from Metrohm.
Anyone who picks up a smartphone or tablet nowadays can almost take it for granted that it contains an HDI printed circuit board from AT&S, one of the world’s leading manufacturers of high-quality PCBs for the Mobile Devices sector. AT&S has concentrated the manufacture of these high-tech products at its plant in Shanghai. As far as the monitoring and optimization of the coating process in the acidic copper bath are concerned, wet chemical analytical techniques such as titration and cyclic voltammetric stripping (CVS) play an important role. In this area AT&S in Shanghai relies on systems from Metrohm. Do it yourself – that’s the fastest approach when it comes to the installation, operation, and maintenance of your Metrohm System. However, this is done best with proper instruction. To this end you find a complete range of 'how to' videos in the «support» section on the homepage of Metrohm International Headquarters. These videos demonstrate step by step how your Metrohm analyzer is correctly installed, operated, and maintained...
Do it yourself – that’s the fastest approach when it comes to the installation, operation, and maintenance of your Metrohm System. However, this is done best with proper instruction. To this end you find a complete range of 'how to' videos in the «support» section on the homepage of Metrohm International Headquarters. These videos demonstrate step by step how your Metrohm analyzer is correctly installed, operated, and maintained... WesTrac Group, based in Tianjin (China), is one the world’s largest dealers of Caterpillar heavy machinery. In their SOS lab in Tianjin they check crucial parameters in oils and lubricants in order to ensure the optimum safety and performance of Caterpillar products. Automated Metrohm instruments for TAN and TBN control as well as for water content according to Karl Fischer contribute significantly to the high-quality results that WesTrac’s SOS lab depends on...
WesTrac Group, based in Tianjin (China), is one the world’s largest dealers of Caterpillar heavy machinery. In their SOS lab in Tianjin they check crucial parameters in oils and lubricants in order to ensure the optimum safety and performance of Caterpillar products. Automated Metrohm instruments for TAN and TBN control as well as for water content according to Karl Fischer contribute significantly to the high-quality results that WesTrac’s SOS lab depends on... Metrohm is introducing a new amperometric detector, which complements the portfolio of intelligent ion chromatography instruments. It may always be used when electroactive substances are to be determined. This is a highly selective and sensitive method, giving reliable analyses down to the ng/L range...
Metrohm is introducing a new amperometric detector, which complements the portfolio of intelligent ion chromatography instruments. It may always be used when electroactive substances are to be determined. This is a highly selective and sensitive method, giving reliable analyses down to the ng/L range... OEL CHECK GmbH in Brannenburg (Germany) is a big contract lab specializing in the analysis of oils and lubricants. They use thermometric titration on Metrohm’s 859 Titrotherm to determine TAN and TBN. OEL CHECK GmbH and Metrohm are currently working together to have thermometric titration standardized by DIN and ASTM...
OEL CHECK GmbH in Brannenburg (Germany) is a big contract lab specializing in the analysis of oils and lubricants. They use thermometric titration on Metrohm’s 859 Titrotherm to determine TAN and TBN. OEL CHECK GmbH and Metrohm are currently working together to have thermometric titration standardized by DIN and ASTM... The Aquatrode plus with plug-in head U from Metrohm was specially developed for measurements and titrations in low-ion and poorly buffered samples, such as surface waters and deionized water.
The Aquatrode plus with plug-in head U from Metrohm was specially developed for measurements and titrations in low-ion and poorly buffered samples, such as surface waters and deionized water. Metrohm complements its portfolio of intelligent ion chromatography systems with an amperometric detector. As an alternative to conductivity and UV/VIS detectors it can always be used when electroactive (i.e. oxidizable or reducible) components are to be determined. The new amperometric detector excels by its high selectivity and measurement sensitivity. It can be used for sensitive and accurate determination of concentrations down to the ng/L-range.
Metrohm complements its portfolio of intelligent ion chromatography systems with an amperometric detector. As an alternative to conductivity and UV/VIS detectors it can always be used when electroactive (i.e. oxidizable or reducible) components are to be determined. The new amperometric detector excels by its high selectivity and measurement sensitivity. It can be used for sensitive and accurate determination of concentrations down to the ng/L-range. Metrohm presents the 898 XYZ Sample changer, an XYZ automate for the fast and reliable analysis of large sample series. Measurements and titrations are carried out directly in the sample vessels. High throughput, plenty of space for 82 samples, the possibility to change racks during operation plus the system being controled by the tiamo software make the 898 XYZ Sample Change the ideal solution for routine analysis...
Metrohm presents the 898 XYZ Sample changer, an XYZ automate for the fast and reliable analysis of large sample series. Measurements and titrations are carried out directly in the sample vessels. High throughput, plenty of space for 82 samples, the possibility to change racks during operation plus the system being controled by the tiamo software make the 898 XYZ Sample Change the ideal solution for routine analysis... Metrohm is pleased to introduce the Ti-Touch, the new compact titrator for routine analysis. The Ti-Touch, which is available for Karl Fischer titration (915 KF Ti-Touch) and potentiometric titration (916 Ti-Touch), sets the new standard for stand-alone titrators. The key-features and user benefits speak for themselves...
Metrohm is pleased to introduce the Ti-Touch, the new compact titrator for routine analysis. The Ti-Touch, which is available for Karl Fischer titration (915 KF Ti-Touch) and potentiometric titration (916 Ti-Touch), sets the new standard for stand-alone titrators. The key-features and user benefits speak for themselves... The big difference between conventional analog electrodes and Metrohm iTrodes is the connection and data communication with the titrator. Behind this are the iTrodes’ memory chip and a miniaturized analog/digital converter (the 854 iConnect) that sits right in the electrode cable head...
The big difference between conventional analog electrodes and Metrohm iTrodes is the connection and data communication with the titrator. Behind this are the iTrodes’ memory chip and a miniaturized analog/digital converter (the 854 iConnect) that sits right in the electrode cable head... Metrohm has become synonymous with water analysis. From February 1, 2011 through June 30, 2012 Metrohm offers 3 all-in-one IC systems that are 100% geared to professional water analysis. During this time, customers benefit from highly valuable equipment (MagIC Net™ software, column, ultrafiltration equipment, inline eluent preparation) that Metrohm gives away with each of the three packages – absolutely free!
Metrohm has become synonymous with water analysis. From February 1, 2011 through June 30, 2012 Metrohm offers 3 all-in-one IC systems that are 100% geared to professional water analysis. During this time, customers benefit from highly valuable equipment (MagIC Net™ software, column, ultrafiltration equipment, inline eluent preparation) that Metrohm gives away with each of the three packages – absolutely free! Metrohm is pleased to introduce the 910 PSTAT mini, a PC-controlled, small and compact potentiostat ideally suited for training and simple applications in R&D. The PSTAT software is simple and intuitive to use enabling the main electrochemical measuring techniques, i.e. cyclic voltammetry (CV), differential pulse voltammetry (DP), square wave voltammetry (SWV) and chronoamperometric detection (AD).
Metrohm is pleased to introduce the 910 PSTAT mini, a PC-controlled, small and compact potentiostat ideally suited for training and simple applications in R&D. The PSTAT software is simple and intuitive to use enabling the main electrochemical measuring techniques, i.e. cyclic voltammetry (CV), differential pulse voltammetry (DP), square wave voltammetry (SWV) and chronoamperometric detection (AD). he 864 Robotic Balance Sample Processor TAN/TBN offers fast and convenient sample preparation combined with the analysis of petrochemical products in one system.
he 864 Robotic Balance Sample Processor TAN/TBN offers fast and convenient sample preparation combined with the analysis of petrochemical products in one system. Metrohm presents TitrIC, an all-in-one system for efficient monitoring of standard parameters and contaminants in drinking water. TitrIC combines titration, ion chromatography and direct measurement in a single analytical unit. TitrIC has been developed with a focus on water analysis but can likewise be adapted to suit the needs in food, pharmaceutical and plating analysis.
Metrohm presents TitrIC, an all-in-one system for efficient monitoring of standard parameters and contaminants in drinking water. TitrIC combines titration, ion chromatography and direct measurement in a single analytical unit. TitrIC has been developed with a focus on water analysis but can likewise be adapted to suit the needs in food, pharmaceutical and plating analysis. The real challenge in ion chromatography often is sample preparation. There are many techniques available-which one will do the trick for your sample? Metrohm's new quICk finderTM provides the answer. quICk finderTM helps users to find the right technique for the fully automated preparation of even the most complex samples - in a matter of seconds
The real challenge in ion chromatography often is sample preparation. There are many techniques available-which one will do the trick for your sample? Metrohm's new quICk finderTM provides the answer. quICk finderTM helps users to find the right technique for the fully automated preparation of even the most complex samples - in a matter of seconds Metrohm is pleased to introduce the 885 Compact Oven Sample Changer, a new, economically priced instrument for automated thermal sample preparation in Karl Fischer titration. The 885 Compact Oven Sample Changer excels by a very small footprint, ease of use and its great flexibility. Thus, the new instrument can be used with all stand-alone Karl Fischer titrators with sample table and for volumetric and coulometric titrations alike.
Metrohm is pleased to introduce the 885 Compact Oven Sample Changer, a new, economically priced instrument for automated thermal sample preparation in Karl Fischer titration. The 885 Compact Oven Sample Changer excels by a very small footprint, ease of use and its great flexibility. Thus, the new instrument can be used with all stand-alone Karl Fischer titrators with sample table and for volumetric and coulometric titrations alike.